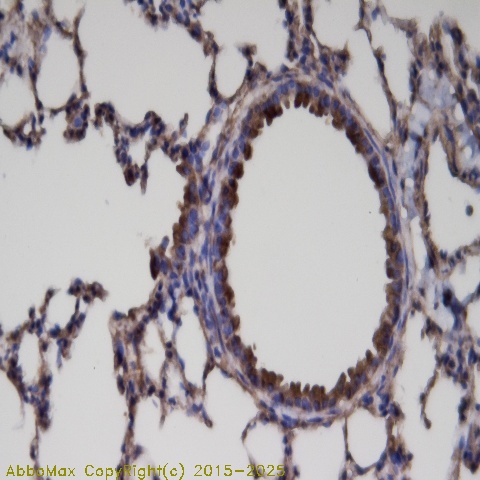

ER81
ets variant gene 1; Etsrp81; ets related protein 81
 Download Product PDF
Download Product PDF
 MSDS Download Product PDF
MSDS Download Product PDF
Antigen Preparation
"A synthetic peptide corresponding to the C-terminus of human ER81 protein. This sequence is identical within human, rat, mouse, bovine, dog and chicken."
Background
"The ETS transcription factors Ets2, ER81 and Elk1 belong to the Ets transcription factor family. ER81 (also designated ETV1) binds the motif 5'-CGGAA/T-3'. It is a prerequisite for normal development. An abnormal regulation contributes to neoplasia. ER81 is highly expressed in brain, testis, lung and heart. ER81 is also moderately expressed in spleen, pancreas, colon and small intestine. During development, ER81, PEA3 and ERM display unique expression patterns which suggest these transcriptional factors play an important role in organogenesis. ERK-1 activates ER81 transcriptional activity while MAPKAP kinase 2 inhibits ER81. ER81 also can be acetylated at N-terminus (Lys33 and Lys116)."
PURIFICATION
The Rabbit IgG is purified by Epitope Affinity Purification
|
SPECIFICITY
"This antibody recognizes ~56 kDa of ER81 protein. This antibody also reacts with human, mouse and rat. The other species are not tested."
|
FORMULATION
This affinity purified antibody is supplied in sterile Phosphatebuffered saline (pH7.2) containing antibody stabilizer
|
STORAGE
The antibodies are stable for 24 months from date of receipt when stored at –20oC to –70oC. The antibodies can be stored at 2oC-8oC for three month without detectable loss of activity. Avoid repeated freezing-thawing cycles.
|
Applications/Suggested Working Dilutions
|
|
|
Immunoprecipitation
2-5 µg/ml
|
|
Flow cytometry
Not tested
|